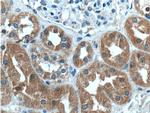
UROD Antibody in Immunohistochemistry (Paraffin) (IHC (P))

Search
Proteintech
UROD Polyclonal Antibody
{{$productOrderCtrl.translations['antibody.pdp.commerceCard.promotion.promotions']}}
{{$productOrderCtrl.translations['antibody.pdp.commerceCard.promotion.viewpromo']}}
{{$productOrderCtrl.translations['antibody.pdp.commerceCard.promotion.promocode']}}: {{promo.promoCode}} {{promo.promoTitle}} {{promo.promoDescription}}. {{$productOrderCtrl.translations['antibody.pdp.commerceCard.promotion.learnmore']}}
产品信息
15547-1-AP
种属反应
宿主/亚型
分类
类型
抗原
偶联物
形式
浓度
规格
纯化类型
保存液
内含物
保存条件
运输条件
产品详细信息
Immunogen sequence: MEANGLGPQ GFPELKNDTF LRAAWGEETD YTPVWCMRQA GRYLPEFRET RAAQDFFSTC RSPEACCELT LQPLRRFPLD AAIIFSDILV VPQALGMEVT MVPGKGPSFP EPLREEQDLE RLRDPEVVAS ELGYVFQAIT LTRQRLAGRV PLIGFAGAPW TLMTYMVEGG GSSTMAQAKR WLYQRPQASH QLLRILTDAL VPYLVGQVVA GAQALQLFES HAGHLGPQLF NKFALPYIRD VAKQVKARLR EAGLAPVPMI IFAKDGHFAL EELAQAGYEV VGLDWTVAPK KARECVGKTV TLQVNLDPCA LYASEEEIGQ LVKQMLDDFG PHRYIANLGH GLYPDMDPEH VGAFVDAVHK HSRLLRQN (1-367 aa encoded by BC001778)
靶标信息
This gene encodes the fifth enzyme of the heme biosynthetic pathway. This enzyme is responsible for catalyzing the conversion of uroporphyrinogen to coproporphyrinogen through the removal of four carboxymethyl side chains. Mutations and deficiency in this enzyme are known to cause familial porphyria cutanea tarda and hepatoerythropoetic porphyria.
仅用于科研。不用于诊断过程。未经明确授权不得转售。
生物信息学
蛋白别名: porphyrinogen carboxylase; unnamed protein product; UPD; URO D; URO-D; UROD; Uroporphyrinogen decarboxylase; uroporphyrinogen decarboxylase (EC 4.1.1.37); uroporphyrinogen III decarboxylase
基因别名: AI323803; PCT; porphyrinogen carboxy-lyase; UPD; Uro-d; UROD
UniProt ID: (Human) P06132, (Mouse) P70697
Entrez Gene ID: (Human) 7389, (Mouse) 22275, (Rat) 29421